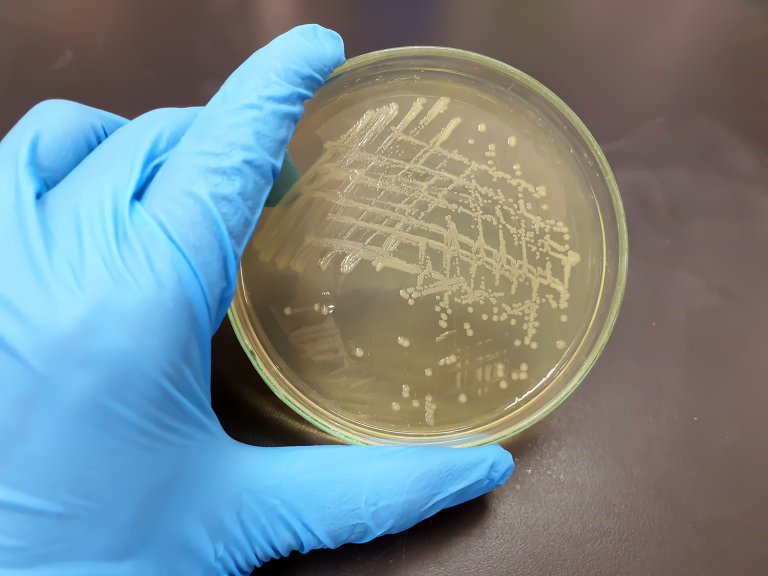
Bakterien Salmonella synlig i en petriskål

Salmonella Newport påvist i alalfaspirer i forbindelse med nasjonalt utbrudd
Veterinærinstituttet har påvist Salmonella Newport i spirer og i produksjonsmiljø hos spireprodusent. Spirene inneholdt Salmonella Newport. Prøvene er tatt i forbindelse med det nasjonale utbruddet av Salmonella Newport.
Det har vært mistanke til at alfalfaspirer har vært smittekilden i utbruddet, og disse prøvene styrker mistanken ytterligere.
Alfalfaspirer lages ved at man lar frøene til planten blålusern spire noen dager. Blålusern er en fôrplante med omfattende dyrking rundt i verden, men det dyrkes lite i Norge. Frøene til spireproduksjon importeres.
Utbrudd av salmonellainfeksjon fra alfalfaspirer er ikke ukjent. Det er kjent at frøene av og til kan være forurenset med salmonellasmitte. Spirene dyrkes i fuktig varme slik at samonellabakterier vil trives og formere seg. Frøene inneholder som regel ikke slike bakterier, men når de gjør det, vil de få gode muligheter til å vokse opp slik at sannsynligheten for at de som spiser spirene blir syke øker.
- Selv om alfalfaspirer inneholder mange sunne stoffer, er de også et risikoprodukt. Siden spirer gjerne brukes i små mengder i salater og som pynt på andre matvarer, kan smitten spres på mange porsjoner selv fra en liten mengde spirer, sier seniorforsker Taran Skjerdal ved Veterinærinstituttet.
- I utbruddssaker benytter man flere metoder enn de som brukes i rutineanalyse. Det er også blitt gjort i dette utbruddet. Veterinærinstituttet har bistått med å tilpasse prøvetakingsmetoder fra produksjonsmiljø, og det er en viktig grunn til at Salmonella ble funnet her, forteller Skjerdal
Salmonellabakterier omfatter mange serotyper, hvor Salmonella Newport er én. Av og til ser man at enkelte partier av råvarer med kjent salmonellarisiko kan være infisert med flere forskjellige serotyper samtidig.